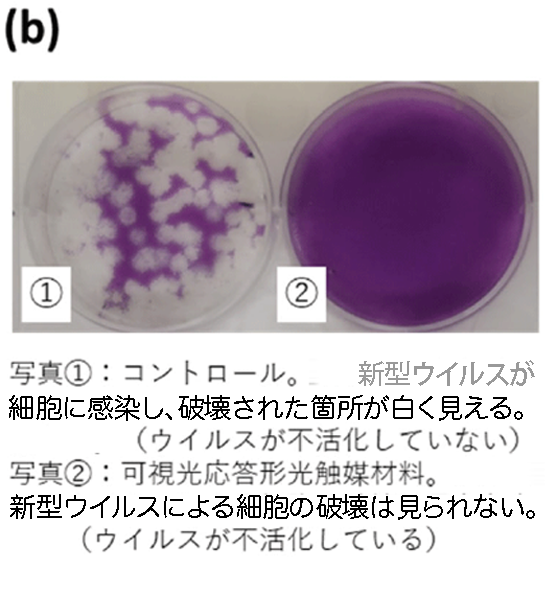
図Bウイルス感染評価結果の一例

よくあるペットのお悩み

臭いが気になる

涙ヤケで茶色に…

ウィルスやバイ菌が
気になる
介護が必要な
ペットがいる
大切な家族でもあるペット。
いつまでも元気でカワイイ姿を見せてほしいものですよね。
でも、動物ならではの繊細な部分はお悩みも尽きないもの。
そんなお悩みをお持ちの飼い主様の為に開発されたのが
「ミナパワー®ペット」です!
使い方もスゴく簡単!
- ❶お散歩から帰った後、気になったらミナパワーをスプレー除菌♪
-

- ❷気になる部分にも。毎日使えばバクテリア等を除去できて真っ白に!
-

- ❸目の周り口の周りはコットンに含ませたクリーナーで塗布しましょう。
-

二度拭き不要! 舐めても無害!
ペットのトイレ・ベッド・洋服・おもちゃ・カート・食器・家具や床にもあらゆものを優しく光のチカラによって除菌分解抗菌していきます。
手足にスプレーしてふき取る、またはティッシュなどにスプレーし涙やけやお口回りを拭いてあげてください。抗菌作用があり匂いも消臭され、色素沈着も改善していきます。
使用上のご注意
目の中に入らないように、また鼻の先にも付かないように気をつけてください。
浸漬洗浄の場合、アルミ、銅、銀製品は短時間にしてください。
お子様の手の届かない所に保管してください。
食器を密閉して、涼しく換気の良い場所で保管してください。
同社製品の「minaPower」「minaPower500」はペット用ではありませんのでご注意下さい。

ミナパワー®のヒミツ
光触媒のコト
光触媒は酸化チタンで構成されており、太陽光などが当たると、その表面で強力な酸化力が生まれて、接触してくる有機化合物や細菌などの有害物質を除去することができる特徴を持っています。
ミナパワー®は、新型光触媒を開発し、太陽光線(紫外線)があたらない室内でも照明などの光源で光触媒反応を十分に行うことが可能になるように設計開発されています。
※ミナパワー®ペットはこのミナパワーの強力な光触媒の機能を生きたペット用に再開発されたペット用ミナパワーです。
光触媒の仕組み
有機化合物を強力に吸着、可視光で分解

新型光触媒の抗菌・抗ウィルス・消臭性能をペット用に再開発
-
身近な
有機物血液・涙ヤケ・便による着色
落ちにくい
色汚れ -
目に見えない
有機物カビ・大腸菌など。各種細胞・ノロウィルスなど
細菌やウィルス
臭い汚れ -
有機有害
物質NoxやPM2.5など窒素酸化物・トルエンなど有機溶剤
窒素酸化物・有機溶剤
有害物質
新型光触媒のチカラで
分解除去!

優れた抗菌・抗ウィルス力
ノロウィルス同様にさっきんが困難な芽胞菌まで分解除去します。暗所ではアパタイトが吸着し光が当たると分解を開始します。
ミナコート加工品の芽胞菌に対する抗菌試験結果(単位:個/試験品)
| 試験条件 | 試験品 | 作用時間 | 抗菌 活性値 | ||
|---|---|---|---|---|---|
| 直後 | 24時間 | 48時間 | |||
| ブラックライト 20W*2本 | 無加工ガラス板a | 1,700 | 1,500 | 120 | 2.0 |
| 「ミナコート」加工ガラス板 | 210 | 1 | |||
| 暗所 | 無加工ガラス板 | 2,800 | 48,000 | ||
| 「ミナコート」加工ガラス板 | 2,100 | 1.600 | |||
その他の働き
- 毒素を分解無害化
・O-157対策 ・黄色ブドウ球菌対策など - 有害VOCの分解無害化
・シックハウス対策 - 汚れの定着を防ぐ
- 消臭効果を長期間持続



安全・安心の成分
主原料である二酸化チタン・アパタイトは食品添加物として、チューイングガムや口紅などに使用されている成分で安心してご使用いただけます。
- 酸化チタン(光触媒)※食品添加物認定
- 天然有機酸※過炭酸、クエン酸、リンゴ酸など
- 精製水
- 光触媒除菌抗菌消臭スプレー
- 二酸化チタン、過炭酸、クエン酸、および天然油脂の混合物水溶液
- 透明
- アルカリ性
ペット用に開発されていますので、
アルコールなどの刺激物は含んでいません!

正規の光触媒工業会会員として
認められたの国内企業が製造

色々な所に幅広く活躍!!

床・家具・トイレ


服・ベッド

おもちゃ

食器

ペットのトイレ・ベッド・服・おもちゃ・カート・食器・家具や床にも、あらゆるものを優しく光の作用でウィルスや菌は分解され除菌抗菌!
抗菌作用があり匂いも消臭され、清潔に保てます。
ウィルスに関する研究資料およびレポート
【重大ニュース】可視光応答形光触媒による新型ウイルス不活化を確認
東京工業大学(物質理工学院 材料系 宮内雅浩教授)、奈良県立医科大学(微生物感染症学講座 中野竜一准教授)
神奈川県立産業技術総合研究所(研究開発部 抗菌・抗ウイルス研究グループ)の研究グループは
世界で初めて可視光応答形光触媒材料(CuxO/TiO2)による新型ウイルスの不活化を確認しました。
その不活化条件を実験的に明示することにより、光触媒による抗ウイルス効果を学問的に示しました。
研究成果
- 本光触媒材料に光照射をすることで、1時間で2.5桁のウイルス量の減少(99.7%の減少)、
2時間で検出限界以下である99.99%以上のウイルス量が減少しました。 - また、暗所においても4時間で検出限界以下に減少させることを明らかにしました。
- このことから、本光触媒材料を利用することで、新型ウイルスを不活化できることがわかりました。
- 本研究成果をもとに、学校、病院やその他多くの人が利用する公共施設等における飛沫の付着や人が触れる場所に対して、
持続的な抗ウイルス効果を付与させることが可能になると考えられます。

>ウイルス研究成果の詳細ページはこちらになります。<
| 表. ウイルス(バクテリオファージ)と細菌の違い | ||
|---|---|---|
| 性質 | ウイルス(バクテリオファージ) | 細菌 |
| 自己増殖 | できない (宿主の力を借りて増殖) |
できる |
| エネルギー産生 | 出来ない | 出来る |
| 核酸 | DNAまたはRNAの片方 | DNAとRNAの両方 |
| 大きさ | 0.02~0.2 μm (20~200 nm) | 1~10 μm |
| 構造 |
非細胞
|
単細胞生物 核酸 細胞壁 細胞膜 細胞内外タンパク質 |
ウイルスの分類(エンベロープあり/なし)
表に示したように、ウイルスの構造からエンベロープ(脂質二重膜)をもつウイルスとエンベロープを もたないウイルスに大きく分類される。エンベロープをもつウイルスは、たとえばインフルエンザウイルス (図1)であり、バクテリオファージでは、φ6バクテリオファージである。それに対し、エンベロープをもた ないウイルスの一例はノロウイルス(図2)であり、バクテリオファージでは、光触媒の抗ウイルス評価に 用いるQβバクテリオファージである。


光触媒による抗ウイルスのメカニズム
光触媒作用により発生した活性酸素種が、ウイルスの外膜(エンベロープあるいはカプシド)を 酸化分解することにより、ウイルスの活性(感染能)を抑制する。

光触媒による抗ウイルスメカニズムの特徴
- 光触媒による酸化分解には、分解対象の選択性がないため、ウイルスの種類にかかわらず 効果を発揮することが期待できる。ウイルスの突然変異の影響も、ほとんど受けないと考え られる。
- エンベロープを持たないウイルスは、一般的に消毒薬等に対する耐性が高いとされているが、 光触媒はエンベロープの有無に関わらず抗ウイルス効果を発現することが確認されている。
- 光触媒による抗ウイルス作用は、光触媒の表面のみで起こる。気中のウイルスへの効果は、 気中から光触媒表面に接触したウイルスについては不活化作用を期待できる。
光触媒の「抗ウイルス」の定義について
光触媒工業会において、「(光触媒の)抗ウイルス」とは、「光触媒の表面において、 ウイルスの活性(感染能)を抑制する状態」をいう。
- 光触媒の抗ウイルスの効果は、指標となるバクテリオファージQβ(NBRC 20012) への効果を評価したものであり、ウイルス全般への効果を期待できるが、全ての ウイルスあるいは特定のウイルスに対する効果を保証するものではない。
- 病気の予防や治療効果を示すものではない。
- 光触媒の抗ウイルスの効果は光触媒の表面で発現するものであり、空間への 直接の効果を示すものではない。
光触媒抗ウイルスの製品認証は、最終製品の性能評価結果に対して判定されるものである。
バクテリオファージQβを用いる理由
光触媒の抗ウイルスの効果は、JIS R 1706およびJIS R 1756で規定されている とおり、ウイルスの一種であるバクテリオファージQβ(NBRC 20012)をウイルスの 代替指標として試験に用いることとした。
- 光触媒による抗ウイルスのメカニズムから、光触媒による抗ウイルスの効果は、動物ウイルスに対し てもファージに対しても同様に期待できる。
- バテクリオファージQβは、一般に消毒薬等に対する耐性が高いとされるエンベロープなしに分類 される。そのため、バテクリオファージQβを用いる試験は、厳しい側の評価と言える。
- 光触媒の抗ウイルスの効果について、代表的な動物ウイルスに対する効果とバクテリオファージQβ に対する効果の相関性は、NEDO「循環社会構築型光触媒産業創成プロジェクト」やJIS R 1706 制定委員会あるいは光触媒工業会標準化委員会抗ウイルス部会によって、データが蓄積されている。
- 動物ウイルスを用いる試験では、安全対策の必要性があるほか、試験時の夾雑物の影響が大きく、 試験の精度や再現性に問題が生じる場合が多い。一方、バクテリオファージQβは人体に対して無害 であるとともに、夾雑物の少ない高濃度の培養液を得やすいため試験の精度・再現性が高い。
以上から、光触媒は、バクテリオファージQβに対して明確な抗ウイルスの効果を示すことが評価できれ ば、動物ウイルスを含むウイルス全般に効果があることを期待できる、また性能を判定する標準試験と しては試験の精度・再現性が高いバクテリオファージQβを用いるべきと判断した。
動物ウイルスとファージに対する効果相関性
光触媒抗ウイルスの効果の動物ウイルスおよびファージに対する相関性を示す データを以下に示す。
紫外光型光触媒加工サンプルにおける各種動物ウイルスとバクテリオファージQβに対する抗ウイルス活性値の相関性





購入はコチラ




